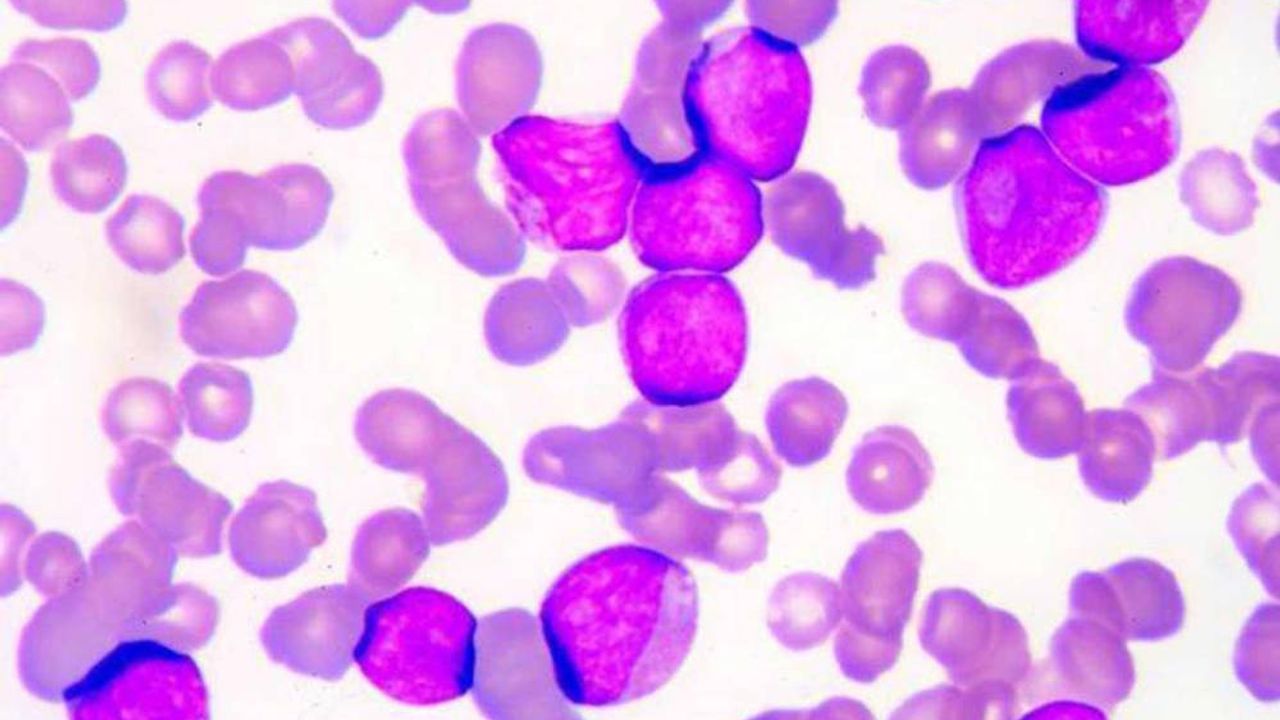

Erken teşhis ile tedavi şansı oldukça yüksek olan hastalığın erken dönemlerde fark edilmesi ve tedaviye başlanması büyük önem taşıdığı belirtiliyor.
Diğer kemik iliği hastalıkları belirtileri ile benzerlik gösteren löseminin en belirgin bulguları arasında kansızlığa bağlı olarak gelişen halsizlik, solgunluk, çabuk yorulma ve nefes darlığı bulunur.
Bağışıklık sisteminin zayıflaması nedeniyle ortaya çıkan enfeksiyonlar ve trombositlerin etkilenmesine bağlı olarak oluşan burun, diş ve diş eti kanamaları, cilt altında beklenmedik kanamalar, morarmalar ve cilt üzerinde toplu iğne başı büyüklüğünde kırmızı döküntüler (peteşiler) lösemi belirtileri arasında yer aldığı ifade ediliyor.
İştahsızlık, kilo kaybı, gece terlemeleri, tedavi ile kontrol altına alınamayan ateşli enfeksiyonlar, kemik ağrıları, boyun ve koltuk altı lenf bezlerinde büyüme, diş etlerinde ve karında şişlikler ise özellikle akut lösemi belirtileri arasında kabul edilen bulguları oluşturduğu kaydedildi.